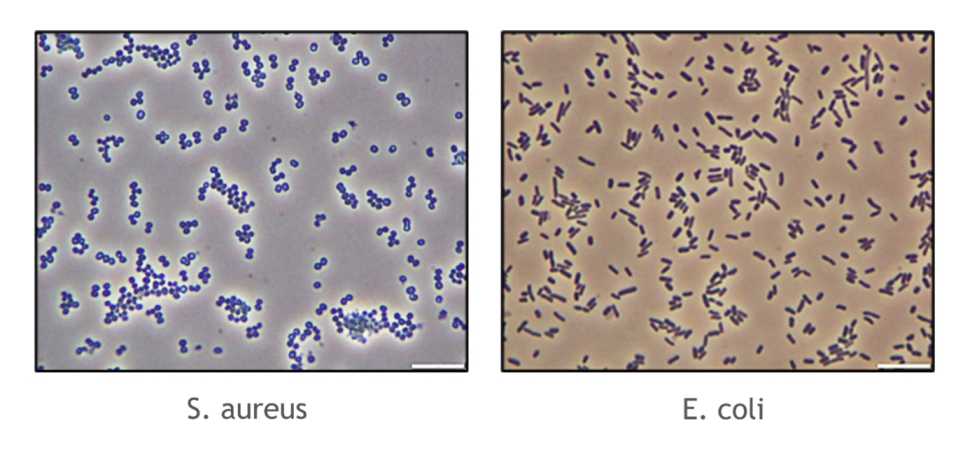

We are living with microorganisms all around us. These are essential for our health but also for many applications as in the cosmetic industry. We are using them to ensure that the cosmetic products that are going on the market can be stable for contamination over the time. What are the applications of microbiology in cosmetics? What is preservation of cosmetic products? Let’s focus first on what is microbiology.
What is the main importance of microbiology?
The microbiology is the study of the micro-organisms. It combines all the microscopic organisms which are classified depending of the species. What are the 4 types of microorganisms in cosmetology ? bacteria, mold, parasite or virus.
Micro-organisms are an extremely diverse group of microscopic organisms. They are all different depending of their composition, shape, size and way of life.
You can find them everywhere, in our environment, like in the water or in our soil but also on each part of our bodies like on our skin or in our gut. The microorganism can be used in a positive way, such as in the production of fermented foods and drinks, but they are also the origin of inflammation and diseases.
Like all living things, they need a source of energy to grow and multiply. In laboratories, there are culture media that provide all the nutrients they need to grow properly. Incubated at the right temperature, after a few days, some colonies appear on Petri dishes that’s the case for bacteria. For mold, the growth is represented by a "web of roots" named thallus.
The macroscopic observation of the appearance of the colonies enables us to differentiate between colonies of contaminating bacteria and those we are trying to isolate.
It exists a multitude of criteria to identify a microorganism. To investigate, specific media called « selective media » are used to restrict the growth of certain strains. The difference of composition from one media to the other will be the key to obtain a selective microorganism growth.
To complete an identification process, the use of the microscope can permit to have different shapes of bacteria called cocci or bacilli and different colors : pink or violet which are obtained after a Gram coloration treatment. For example, here we have a cocci Gram + which is S. aureus and a bacilli Gram – which is E. coli.
Why is microbiology important in cosmetics ?
Microbiology is a key parameter for product development and cosmetic safety. Ensuring the product that is going in your bathroom is able to defend itself against external contamination is essential. To avoid microbial contamination in cosmetics, we need to assess each formulation and ask ourselves : What can be a source of nutrients for our microorganisms ? How can we ensure to protect our product to the consumer ?
To cover all these questions, many parameters need to be checked : the content of water and of alcohol inside the formulation, the stability of the formulation depending of the ingredient that are added. Indeed, these checks need to be done to avoid the microbial growth in cosmetic products.
The meaning of these results is that the formulation is not stable and can impact the consumer health. That is the reason why the product protection of the cosmetic product is essential.
More and more preservatives are pushed away from the formulations due to regulatory pressure and consumer opinion. The trend of naturality is really challenging for the microbiology preservation. Alternative preservatives, natural extracts, sustainable packaging or also high natural content means new challenges to ensure the protection of the final product. There are mandatory tests that need to be done to ensure the cosmetic safety.
What are the methods of cosmetic microbiology test ?
The microbiology cosmetics is driven by some tests such as : microbial limits acceptance (qualitatively or quantitatively), microbiology cosmetic risk assessment and preservative efficacy test. What is preservation of cosmetic products ? The cosmetic preservation is a balance to find between product protection and safety for the consumer.
The meaning of this preservative efficacy test for example according to ISO 11930 is to ensure that the cosmetic product is well protected from microbial spoilage. To ensure that the formula will be able to defend itself over time and consumer uses, five microorganisms are selected to be added to the formulation to mimic the real life.
Each of them has been chosen for good reason. One is for water control, another is for air control, there is 2 for human contamination and the last one is to control the hygienic level. After 33 days of experiment, it enables the formulator to determine if the formula is enough robust to scale up.

The preservative efficacy test (PET) permits the in-vitro evaluation of how much product protection the formulation needs and the efficacy of preservatives and multifunctional ingredients (combinations). Over more than 30 years, SYMRISE is bringing solutions that are effective in preventing the microbial growth in cosmetics, with the moto : “Doing more with less for cosmetics”.
How to rethink cosmetic preservation with modern product protection solutions ?
The product protection portfolio developed by Symrise, is composed of multifunctional ingredients that have a real impact on the microbiological stability of the finished product. What is the main importance of microbiology in cosmetics ? In fact it is to find the right product protection combination to avoid the microbial contamination in cosmetics.
Within a wide range of multifunctional ingredients suitable for modern product protection, Symrise offers :
• The diols family which is composed of Hydrolites® range (from 5 to 8) synthetic or organic origin ;
• Symsave® H ;
• and new ones as Savelite® HB and the Mindera® plateform.
To ensure the cosmetic safety, Symrise is compiling in a database all preservative efficacy tests results obtained during testings of cosmetics. This plateform is HOGO. Symrise has incorporated its comprehensive knowledge as a leading supplier of cosmetic ingredients into the innovative online platform. Users can easily search for ingredients, efficacy data, a wide range of potential combinations and dosage at any time with HOGO by Symrise – regardless of where they are located. The platform utilizes filters to find solutions that fulfil global regulatory requirements. This helps formulators to develop the best possible product protection system for modern cosmetics. High effectiveness can be achieved by combining our Hydrolite® range with SymSave® H, for example to ensure a broad spectrum efficacy. Symrise is also sharing inspirational formulas throught SymSelect website to guide the customers in their formulation development.
The combination of multifunctional ingredients with other ingredients & conditions can provide more powerful product protection. Symrise’s Symshield® technology explores chemical and physical factors that can optimize and enhance the product protection performance of multifunctionals. The technology allows formulators to maximize the power of multifunctionals and use them more effectively and at lower concentrations in their products.
Symrise Cosmetic Ingredients has also launched an online training series called "The Secret Heroes of Personal Care". Available on YouTube, experts from the market leader for cosmetic ingredients convey in depth insights about product protection in beauty products. With engaging animations and stories, they aim to inform those who want to learn more about the science behind their favourite cosmetic products.
Article written by Marine LOUAIZIL, Microbiology Laboratory Manager, Symrise
